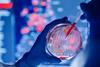
Sandle-Raman-FI

All Raman Spectroscopy articles
-
 Opinion
OpinionReal-time Raman spectroscopy closes bioprocess control measurement gap
Manual sampling cycles leave bioreactor control decisions hours behind culture dynamics. Process Raman spectroscopy offers continuous, real-time measurement of critical parameters, enabling true closed-loop control in perfusion and continuous bioprocessing applications where measurement lag directly impacts yield and product quality.
-
 News
NewsAbbVie expands US footprint with new $1.4 billion manufacturing campus
Small volume parenteral (SVP) manufacturing investment represents company’s largest capital investment to date.
-
 Article
ArticleRaman spectroscopy market reaches $2.35bn driven by pharma
A recent market report projecting the combined NIR and Raman spectroscopy sector will reach $2.35 billion in 2026 underscores the rapid adoption of vibrational spectroscopy across biopharmaceutical manufacturing, with AI-enhanced Raman tools increasingly being deployed for real-time quality control.
-
 Article
ArticleEuropean Pharmaceutical Review Issue 4 2024
European Pharmaceutical Review Issue 4 includes articles on regulation, bioproduction, environmental monitoring, packaging and drug delivery.
-
 Whitepaper
WhitepaperApplication note: Validating recombinant cascade reagents in 3 simple steps
Endotoxin testing continues to evolve alongside the industry’s need for more sustainable methods that reduce ecological impact. Nicola Reid, Associate Director of Endotoxin Products, Charles River Labs, reflects on these developments which are driven by the 3Rs (replacement, reduction and refinement).
-
 Article
ArticleEuropean Pharmaceutical Review Issue 1 2024
EPR Issue 1 includes articles on separation & purification, process analytical technology and drug delivery. Register your details now to download this exclusive content.
-
 News
NewsRaman and machine learning show promise for online monitoring of bioreactors
The approach applied in the research on bioreactors represents a significant advancement over traditional methods, according to the researchers.
-
 Article
ArticleEuropean Pharmaceutical Review Issue 5 2023
EPR Issue 5 includes articles on microbiological testing of ATMPs, the use of inline Raman spectroscopy for bioprocess control, paediatric drug formulation, and more.
-
 Article
ArticleUncovering new frontiers in microbiology and EM
In this Q&A, Laure Pomares Voisin, Quality Director, Catalent Biologics and Tony Cundell Principal Consultant, Microbiological Consulting, LLC discuss some of the key microbiology and environmental monitoring challenges and trends in pharmaceutical manufacturing today.
-
 Article
ArticleLeveraging PAT for environmental monitoring in light of Annex 1
The pharma industry’s adaptation to Industry 4.0 has been slow, due to the extensive regulatory requirements imposed on manufacturers. However, regulatory agencies are starting to embrace movement towards more rapid/automated systems, as illustrated in the revised EU GMP Annex 1, which entered into force in August. Here, Isabella Jul-Jørgensen from ...
-
 News
NewsHow can PAT help advance biologics manufacturing?
Lonza’s Associate Director of R&D has offered insight on implementing process analytical technology (PAT) into biologics manufacturing using real-world examples.
-
 Whitepaper
WhitepaperProduct hub: Bioprocess monitoring made simple with Ramina Process Analyzer
An all in-one system purpose-built for rapid deployment, ease of use and scalability in markets where time-to-results is critical.
-
Whitepaper
Application note: Rapid identification of Polysorbates 20 and 80 through amber bottles
How the Vaya handheld Raman spectrometer differentiates and identifies PS 20 and PS 80 with spatially offset Raman spectroscopy (SORS) technology.
-
Article
ArticleShining a light on Raman for microbiological analysis
The detection and identification of bacteria is essential for biopharmaceutical production, the assessment of new antimicrobials and assessing contamination control measures. Developing methods for complex environments is challenging due to interference from the various molecules present. Here, pharmaceutical microbiologist and contamination control expert Dr Tim Sandle explains how Raman spectroscopy ...
-
 Article
ArticleEuropean Pharmaceutical Review Issue 1 2023
EPR Issue 1 includes articles on the future of pharmaceutical microbiology, separation and purification of complex biologics, the latest on nitrosamines and more...
-
 Article
ArticlePharmaceutical microbiology: key developments 2022
Here, microbiology experts Tim Sandle, Tony Cundell and AstraZeneca’s Miriam Guest reflect on key developments in pharmaceutical microbiology during 2022.



